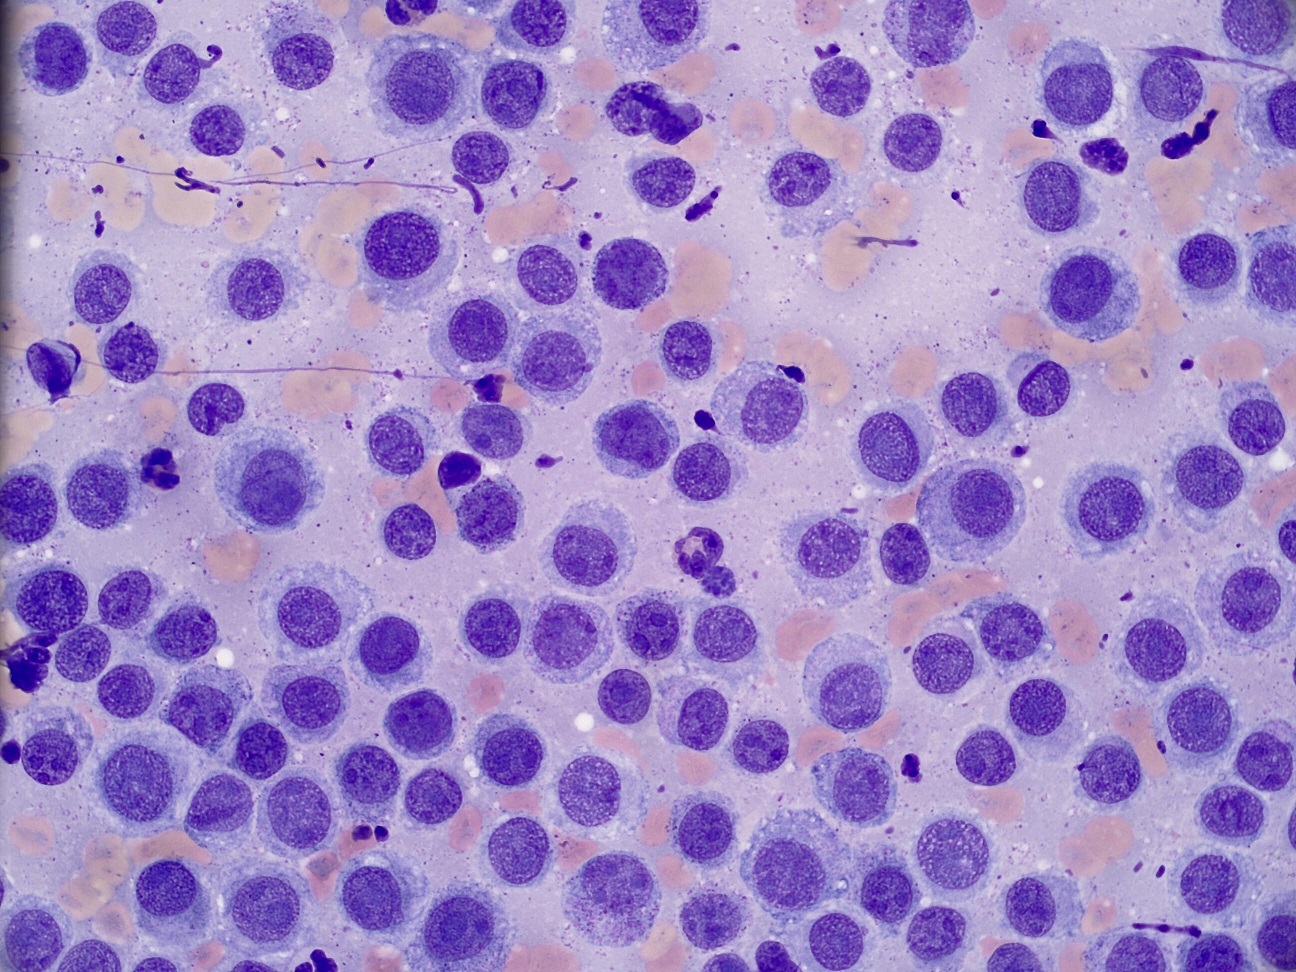

细胞学肿瘤鉴定指南
香港城市大学兽医诊断实验室 (CityU VDL) 与悉尼大学兽医学院四年级学生 Alex Teh 合作,很高兴与大家分享这份关于肿瘤细胞学特征的简要指南。Alex
对解剖病理学和临床病理学有着浓厚的兴趣,并希望在兽医学院毕业后继续深造这些领域。CityU VDL 通过悉尼大学 2021 年兽医博士生导师计划 (DVM
Mentoring Program) 结识了 Alex。
本指南包含如何区分组织细胞类型、恶性肿瘤的诊断标准,并提供了一些犬猫常见肿瘤的实例。
点击链接即可阅读。